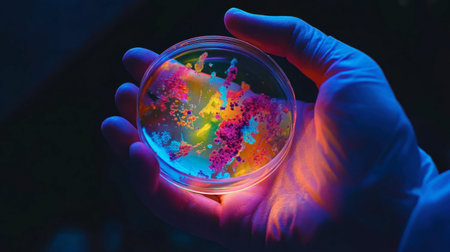
A close-up of a hand holding a colorful Petri dish illuminated with vibrant light, showcasing fascinating bacterial growth in a laboratory setting.の素材

素材 - A close-up of a hand holding a colorful Petri dish illuminated with vibrant light, showcasing fascinating bacterial growth in a laboratory setting.
作品情報
A close-up of a hand holding a colorful Petri dish illuminated with vibrant light, showcasing fascinating bacterial growth in a laboratory setting.
- ID:258151729
- 作品種別:
- 作者名:puttipong songsanket
キーワード
- analysis
- background
- bacteria
- biology
- cell
- chemistry
- colorful
- culture
- detail
- development
- discovery
- education
- environment
- experiment
- growth
- hands
- health
- healthcare
- illumination
- innovation
- investigation
- lab
- laboratory
- light
- medical
- microbiology
- modern
- nature
- observation
- organic
- patterns
- petri dish
- professional
- quality
- research
- science
- scientist
- specimen
- study
- technology
- testing
- texture
- visual
- vivid
類似作品
burnt grass in ...
A hand simulate...
male hand of fa...
Hand of a man r...
Hand off water ...
Close up of han...
closeup man han...
closeup of hand
happy pretty gi...
Hand reaching o...
Out of focus is...
The guy watches...
small boy makin...
open hand on wh...
dusty man hand ...
Human touching ...
Two hands holdi...
Hands reaching ...
Offering help. ...
Grandma's hand ...
detail of Cross...
Woman open hand...
sign need help....
Adult and child...
Hand of the con...
index finger on...
Girl looks at t...
Follow me, Happ...
Hand with engag...
Help concept ha...
Beautiful view ...
the palm at the...
Father and son ...
Woman reaches h...
Young woman wit...
A hand reaching...
Violent crimina...
Man's hand on a...
Hand
intertwined han...
Close up of mal...
a person's hand...
Holding and tou...
A woman holding...
Couples holding...
The isolated sh...
Married couple ...
Both hands gest...